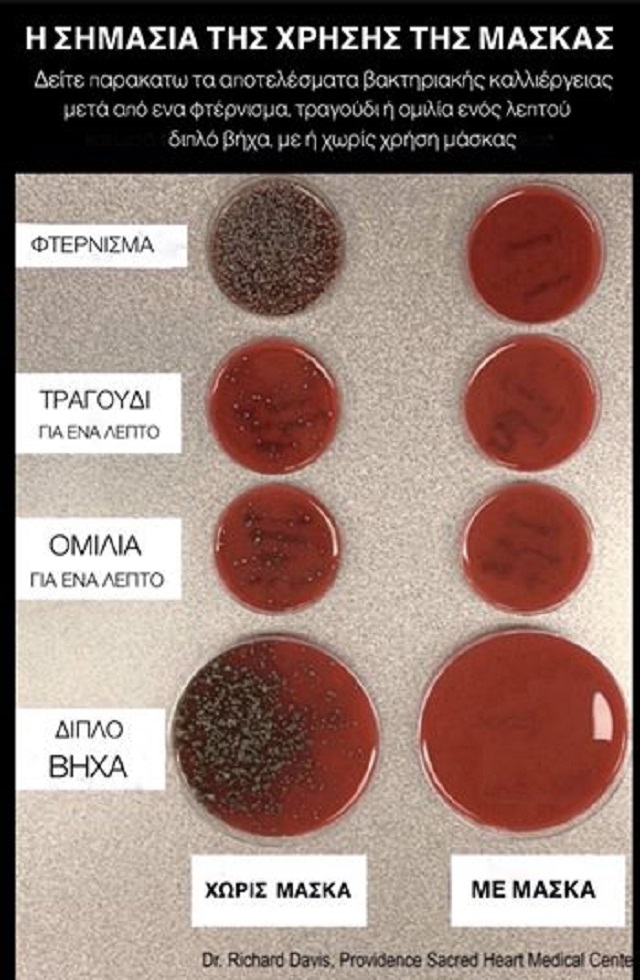

ΔΕΙΤΕ ΠΡΩΤΟΙ ΟΛΑ ΤΑ ΝΕΑ ΤΟΥ TRIBUNE ΣΤΟ GOOGLE NEWS
Διαβάστε σχετικά για Ηλίας Μόσιαλος, Κορωνοϊός - Κορονοϊός,


















































Καίγονται πετρελαιοπηγές στην Ανατ. Συρία
Μαρέβα Μητσοτάκη: Χειρουργήθηκε και στα δύο χέρια στο ΚΑΤ μετά από σοβαρό ατύχημα
Νίκος Δένδιας από το «The India-EU Forum»: «Το θέμα της Γροιλανδίας έχει ξεπεραστεί» - Η σχέση της Ελλάδας με την
Καθαρισμοί οικοπέδων: Έρχονται μεγάλες αλλαγές με το νομοσχέδιο «Ενεργή Μάχη»
«Βροχή πυραύλων»: Νέα γιγαντοαφίσα στην Τεχεράνη απειλεί το Τελ Αβίβ με πυραυλικά πλήγματα
ΔΕΙΤΕ ΠΡΩΤΟΙ ΟΛΑ ΤΑ ΝΕΑ ΤΟΥ TRIBUNE ΣΤΟ GOOGLE NEWS
Ο Ηλίας Μόσιαλος, με μια φωτογραφία δείχνει το σημαντικό είναι να φοράμε μάσκα όσο ο κορωνοϊός είναι… ακόμα ανάμεσά μας.
Πιο συγκεκριμένα, ο καθηγητής του LSE, Ηλίας Μόσιαλος ανήρτησε μια φωτογραφία που απεικονίζει τα αποτελέσματα της βακτηριακής καλλιέργειας μετά από ένα φτέρνισμα, τραγούδι η ομιλία διάρκεια ενός λεπτού.
Μάλιστα υπάρχουν δύο ειδών αποτελέσματα.
Των ατόμων που φορούσαν μάσκα και όσων δεν φορούσαν.